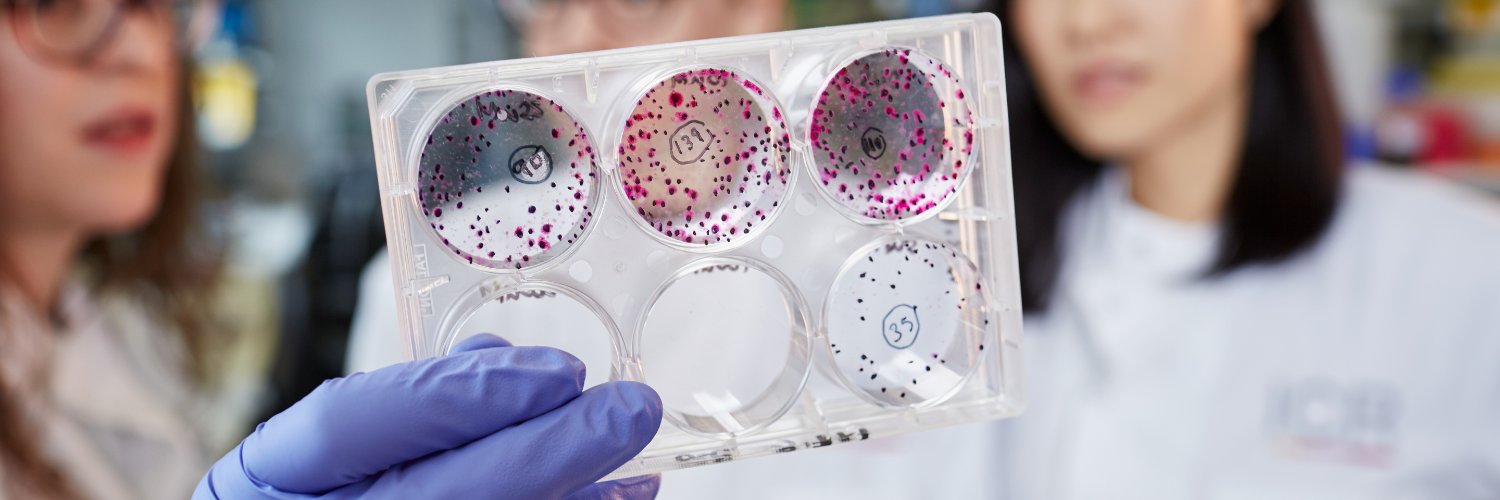
CRIS Cancer Foundation banner

CRIS Cancer Foundation
2.1K posts

CRIS Cancer Foundation
@CRISCANCERUK
Independent non-profit organisation dedicated to fight cancer through research. Invest in Research. Invest in Life.
London, England Katılım Ocak 2015
328 Takip Edilen540 Takipçiler
CRIS Cancer Foundation retweetledi

Today is #InternationalChildhoodCancerDay. Continued investment & support for research is VITAL for better understanding childhood cancers, making new discoveries, & for developing clinical trials which can lead to new treatments. @CRISCANCERUK @ICR_London @JonesLabICR @RCPath
English
CRIS Cancer Foundation retweetledi

A massive well done to our big Greek family! 👏 Yesterday we walked a half-marathon around London, in support of @Pancreaticcanceruk and @CRISCANCERUK - to raise funds and awareness for a cause close to our hearts #WalkTheRealGreek

English
CRIS Cancer Foundation retweetledi

Our immense gratitude to those involved in the success of the event held to raise funds for the @CRISCANCERUK Foundation. A big thank you to Soprano @Ainhoarteta and Chef @QiqeDacosta who showed their commitment in the fight against cancer.

English

@Tradeweb @MillwallFC It was a great honour to be chosen as your charity for this event. The funds will be integrally used to support our CRIS research projects where we work tirelessly to fulfill our vision of a world in which every type of cancer has a treatment. Thank you once again
English
CRIS Cancer Foundation retweetledi

We would like to say a big thank you to all our clients who participated in our annual charity football tournament at @MillwallFC. Supporting causes that make a difference is really important to us, so this year we teamed up with @CRISCANCERUK, raising £3375 which our Tradeweb Cares committee will match. Lastly, a huge congratulations to our 2023 winners J.P. Morgan!
English
CRIS Cancer Foundation retweetledi

Join us on Thursday at 10am for an Instagram Live workshop with leading psychotherapist and best-selling author Julia Samuel. As part of National #DayOfReflection, Julia will be introducing you to breathwork and ways to stay calm to help with grief related trauma and anxiety.💛

English
CRIS Cancer Foundation retweetledi

If you've recently been diagnosed with #wombcancer you can get one of our info packs for free.
Just inbox me your address & I'll pop one in the post. Lots of info & advice & a couple of our contact cards
Please RT.

English

Enrique will run the @tokyo42195_org on March 5th. He is determined to push harder than ever, in training & fundraising & to break his personal best from 2021 & double his last fundraising to reach 15,000 euros. Good luck, Enrique! Donate via the link ow.ly/LAN550N4BiA

English

We are paying tribute to Christos Karatzenis’ life & legacy by #WALKTHEREALGREEK with friends & family we walk in his memory to raise funds & awareness for #pancreaticcancer in partnership with @PancreaticCanUK @RealGreekTweet & VDK
Capital. Donate here: ow.ly/F5Jp50N0teM

English

After 6 years of trying to get a place, Gonzalo finally has the opportunity to run in the Tokyo Marathon 2023. Gonzalo is aiming to raise another £5,000 to help fund cancer research. Good luck, Gonzalo! Please donate if you can here: ow.ly/MSMC50N4zjV

English

We are paying tribute to Christos Karatzenis’ life & legacy by #WALKTHEREALGREEK with friends & family we walk in his memory to raise funds & awareness for #pancreaticcancer in partnership with @PancreaticCanUK @RealGreekTweet & VDK
Capital. Donate here: ow.ly/LWl550N0t5s

English

Copita Soho has partnered with CRIS for the whole month of February to raise funds for lifesaving #CancerResearch. Your small contribution will make a BIG difference. Visit our website to see the other restaurants taking part ow.ly/2HBr50MFA6Y #WorldCancerDay

English

Thanks to YOUR SUPPORT, CRIS Cancer Foundation can fund several children’s oncology projects in the UK, Spain & France. Thank you for giving hope & helping save the lives of children @IntChildCancer #InternationalChildhoodCancerDay read about them here: criscancer.org/en/crispaediat…

English

And if you did get a place in the ballot, you can still fundraise for CRIS! Email info@criscancer.org.uk to find out how you can join our team!
@RoyalParksHalf #criscanceruk #royalparkshalf

English

@barricatapas has partnered with CRIS for the whole month of February to raise funds for lifesaving #CancerResearch. Your small contribution will make a BIG difference. Visit our website to see the other restaurants taking part ow.ly/GaeI50MFkFp
English

@badiani1932 has partnered with CRIS for the whole month of February to raise funds for lifesaving #CancerResearch. Your small contribution will make a BIG difference. Visit our website to see the other restaurants taking part ow.ly/GaeI50MFkFp
#worldcancerday

English

We are proud to fund some of the best #WomenInScience today! Thanks to the generosity of our donors who make it possible. Here is Dr Charlotte Pawlyn, Team Leader of the Myeloma Biology & Therapeutics Team @ICR_London she shares her hope & vision for the future of #cancerresearch
English

@CambiodTercio has partnered with CRIS for the whole month of February to raise funds for lifesaving #CancerResearch. Your small contribution will make a BIG difference. Visit our website to see the other restaurants taking part ow.ly/tmkk50MFqrl
#worldcancerday

English

